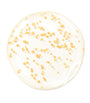
Youth Watery Oil Serum (50ml)

Youth Watery Oil Serum (50ml)
SKU:
Couldn't load pickup availability
Feniel Big Discount Offers Have Begun! Your Special 10% Discount Coupon for This Product: BBG99001T
Details
Product care
Hand or machine wash on a cool, gentle cycle with similar colours. Avoid harsh chemicals or stain removers, which can affect the colour.
Shipping & returns
Shipping:
Standard deliveries are usually delivered within 4-6 working days.
If you choose Express Delivery, your order will be delivered within 2-3 business days.
If you wish, you can also collect your orders from our stores closest to you worldwide.
With our Feniel NOW Service, we deliver to you within a few hours in certain countries only. This option will automatically appear on your order page if it is available in your country.
Return:
You may return any product you are not satisfied with within 30 days, no questions asked.
- Safe Payment
- Free Express Shipping*
- Delivery 2-5 days
CLOTHING SIZE GUIDE
WOMEN
| STANDARD | UK | EU | US | IT | FR | JP | KR | AU |
|---|---|---|---|---|---|---|---|---|
| XXXS | 4 | 32 | 0 | 36 | 34 | 3 | 33 | 4 |
| XXS | 6 | 34 | 2 | 38 | 36 | 5 | 44 | 6 |
| XS | 8 | 36 | 4 | 40 | 38 | 7 | 55 | 8 |
| S | 10 | 38 | 6 | 42 | 40 | 9 | 66 | 10 |
| M | 12 | 40 | 8 | 44 | 42 | 11 | 77 | 12 |
| L | 14 | 42 | 10 | 46 | 44 | 13 | 88 | 14 |
| XL | 16 | 44 | 12 | 48 | 46 | 15 | 99 | 16 |
| XXL | 18 | 46 | 14 | 50 | 48 | 17 | 110 | 18 |
MEN
| STANDARD | UK | EU | US | IT | FR | JP | KR | AU |
|---|---|---|---|---|---|---|---|---|
| XXXS | 30 | 40 | 30 | 44 | 44 | XS | 85 | 30 |
| XXS | 32 | 42 | 32 | 46 | 46 | S | 90 | 32 |
| XS | 34 | 44 | 34 | 48 | 48 | M | 95 | 34 |
| S | 36 | 46 | 36 | 50 | 50 | L | 100 | 36 |
| M | 38 | 48 | 38 | 52 | 52 | LL | 105 | 38 |
| L | 40 | 50 | 40 | 54 | 54 | XL | 110 | 40 |
| XL | 42 | 52 | 42 | 56 | 56 | XXL | 115 | 42 |
| XXL | 44 | 54 | 44 | 58 | 58 | 3L | 120 | 44 |
KIDS
| AGE | UK | EU | US | JP | KR | AU | HEIGHT (cm) |
|---|---|---|---|---|---|---|---|
| 0-3M | 0-3m | 50-56 | 0-3m | 60 | 60 | 0000 | 52-62 |
| 3-6M | 3-6m | 56-62 | 3-6m | 70 | 70 | 000 | 62-68 |
| 6-12M | 6-12m | 62-80 | 6-12m | 80 | 80 | 00 | 68-80 |
| 1-2Y | 1-2Y | 80-92 | 1-2Y | 90 | 90 | 0 | 80-92 |
| 3-4Y | 3-4Y | 92-104 | 3-4Y | 100 | 100 | 2 | 92-104 |
| 5-6Y | 5-6Y | 104-116 | 5-6Y | 110 | 110 | 4 | 104-116 |
| 7-8Y | 7-8Y | 116-128 | 7-8Y | 120 | 120 | 6 | 116-128 |
FOOTWEAR SIZE GUIDE
WOMEN
| UK | EU | US | JP | KR | AU |
|---|---|---|---|---|---|
| 2 | 35 | 4 | 21 | 210 | 4 |
| 3 | 36 | 5 | 22 | 220 | 5 |
| 4 | 37 | 6 | 23 | 230 | 6 |
| 5 | 38 | 7 | 24 | 240 | 7 |
| 6 | 39 | 8 | 25 | 250 | 8 |
| 7 | 40 | 9 | 26 | 260 | 9 |
| 8 | 41 | 10 | 27 | 270 | 10 |
MEN
| UK | EU | US | JP | KR | AU |
|---|---|---|---|---|---|
| 6 | 40 | 7 | 25 | 250 | 6 |
| 7 | 41 | 8 | 26 | 260 | 7 |
| 8 | 42 | 9 | 27 | 270 | 8 |
| 9 | 43 | 10 | 28 | 280 | 9 |
| 10 | 44 | 11 | 29 | 290 | 10 |
| 11 | 45 | 12 | 30 | 300 | 11 |
KIDS
| AGE | UK | EU | US | JP | KR | AU |
|---|---|---|---|---|---|---|
| 0-3M | 0 | 16 | 1 | 8 | 80 | 0 |
| 3-6M | 1 | 17 | 2 | 9 | 90 | 1 |
| 6-12M | 2 | 18 | 3 | 10 | 100 | 2 |
| 1-2Y | 4 | 20 | 5 | 12 | 120 | 4 |
| 3-4Y | 6 | 23 | 7 | 14 | 140 | 6 |
| 5-6Y | 8 | 25 | 9 | 16 | 160 | 8 |
| 7-8Y | 10 | 28 | 11 | 18 | 180 | 10 |
Notify me
Youth Watery Oil Serum (50ml) - Default Title